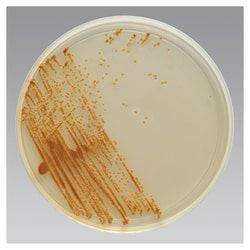
Img

R01152
Thermo Scientific™ Blood Heart Infusion (BHI) Agar with Sheep Blood, Penicilllin and Streptomycin
Manufacturer: Fischer Scientific
The price for this product is unavailable. Please request a quote
Description
BHI Agar w/Sheep Blood, Penicillin, Streptomycin
Format
Monoplate Deep Pour
Product Type
Agar
Quantity
10/Pk.
Description
- Cultivate a wide variety of microorganisms including bacteria, yeasts, and molds with the nutritious base medium Thermo Scientific™ Remel™ Blood Heart Infusion (BHI) Agar with Sheep Blood, Penicilllin and Streptomycin 1
- Isolate fastidious fungi and grow Actinomyces 2 using BHI Agar with 5-10% sheep blood
- Pathogenic fungi and Nocardia asteroides can be isolated using optimal concentrations of chloramphenicol 3
- Cycloheximide inhibits certain Aspergillus spp
- and zygomycetes Use BHI Agar with Sheep Blood, Penicilllin and Streptomycin for the cultivation of a wide variety of microorganisms, including pathogenic fungi
- Highly Nutritious : medium recommended for the enrichment of fastidious organisms
- Ready-to-use : the convenience of prepared media
- Selective : antibiotics allows the selective growth of organisms ( majority of gram-positive flora is inhibited by penicillin and streptomycin)
- Conforms to CLSI standards 4
- BHI Agar w/Sheep Blood contains brain heart infusion, peptone, and dextrose, which provide nitrogen, carbon, sulfur, vitamins and a carbohydrate source
- Sheep blood provides essential growth factors for fastidious fungi
- Yeast extracts are incorporated in the medium to serve as a growth stimulant
- Not all products are available for sale in all territories
- Please inquire
- Remel™ and Oxoid™ products are now part of the Thermo Scientific brand.